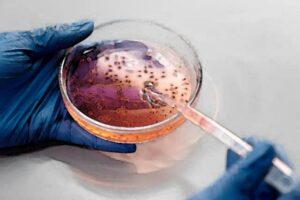

Que signifie rêver de bannière ? Rêver de bannière symbolise l’esprit de groupe, l’appartenance à une communauté et un objectif …
ABC Rêves

Le guide des rêves de A à Z:
Voici le dictionnaire complet et simple de l’interprétation des rêves par lettres :
L’objectif de cette section est de fournir des informations utiles sur les différentes significations des rêves.
Signification et interprétation des rêves:
Trouvez la signification et interprétation de vos rêves des plus courants aux plus étranges en un clin d’œil.
Certains rêves peuvent être prémonitoires et révèlent ce que l’intuition du rêveur voit pendant son sommeil.
Comment interpréter le contenu des rêves et répondre à des questions telles:
- Que signifie rêver qu’une dent tombe ?
- Que signifie rêver d’araignées ?
- Quelle est la signification de rêver avec des serpents ?
- La signification de rêver que vous êtes enceinte, et bien plus encore.

Rêver de bandana : Interprétation & Signification
Que signifie rêver de bandana ? Le bandana est souvent associé à un style particulier ou à une appartenance à …

Rêver de banderole
Que signifie rêver de banderole ? Rêver de banderole est un symbole révélateur de votre état d’esprit actuel. Elle signale …

Rêver de bandages
Que signifie rêver de bandages ? Rêver de bandages est associé à des thèmes de guérison, de protection, et de …

Rêver de germes
Que signifie rêver de germes ? Rêver de germe évoque des thèmes de croissance et de potentiel. Ce symbole riche …

Rêver de microbes : Interprétation & Signification
Que signifie rêver de microbes ? Rêver de microbes reflète souvent des peurs ou des angoisses cachées. Ces rêves évoquent …
Rêver de bactérie : Interprétation & Signification
Que signifie rêver de bactérie ? Sans grande surprise, rêver de bactérie est associé à des thèmes de contamination, d’influence …

Rêver de bascule : Interprétation & Signification
Que signifie rêver de bascule ? Dans l’interprétation des rêve, rêver de bascule est associé à des notions de changement, …

Rêver de ballotter
Que signifie rêver de ballotter ? Rêver de ballotter est le symbole d’une recherche de stabilité et de sécurité. Cela …

Rêver de baluchon
Rêver de baluchon évoque souvent un voyage intérieur ou un changement de vie. Ce symbole reflétera aussi des besoins de …

